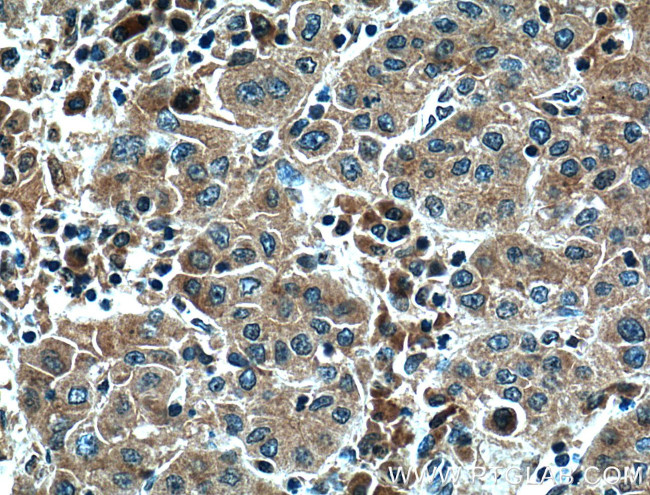
Il2 Antibody in Immunohistochemistry (Paraffin) (IHC (P))

Search
Proteintech
Il2 Polyclonal Antibody
{{$productOrderCtrl.translations['antibody.pdp.commerceCard.promotion.promotions']}}
{{$productOrderCtrl.translations['antibody.pdp.commerceCard.promotion.viewpromo']}}
{{$productOrderCtrl.translations['antibody.pdp.commerceCard.promotion.promocode']}}: {{promo.promoCode}} {{promo.promoTitle}} {{promo.promoDescription}}. {{$productOrderCtrl.translations['antibody.pdp.commerceCard.promotion.learnmore']}}
产品信息
26156-1-AP
种属反应
已发表种属
宿主/亚型
分类
类型
抗原
偶联物
形式
浓度
规格
纯化类型
保存液
内含物
保存条件
运输条件
产品详细信息
Immunogen sequence: APTSSSTSS STAEAQQQQQ QQQQQQQHLE QLLMDLQELL SRMENYRNLK LPRMLTFKFY LPKQATELKD LQCLEDELGP LRHVLDLTQS KSFQLEDAEN FISNIRVTVV KLKGSDNTFE CQFDDESATV VDFLRRWIAF CQSIISTSPQ (21-169 aa encoded by NM-008366)
靶标信息
Interleukin 2 (IL-2) is an immuno-modulatory cytokine that is important for the proliferation of activated T cells, differentiation of B cells, natural killer cells, monocytes and macrophages. IL-2 signals through the IL-2 receptor (IL-2R), a heterotrimeric protein complex whose gamma chain is also shared by interleukin 4 (IL-4) and interleukin 7 (IL-7). The expression of the IL-2 gene in mature thymocytes is monoallelic, which represents an unusual regulatory mode for controlling the precise expression of a single gene. The targeted disruption of a gene similar to IL-2 in mice leads to an ulcerative colitis-like disease that suggests an essential role of this gene in the immune response to antigenic stimuli.
仅用于科研。不用于诊断过程。未经明确授权不得转售。
生物信息学
蛋白别名: aldesleukin; cytokine; H-IL-2; il 2; IL-2; ILN; Interleukin; Interleukin-2; Interleukin2; Involved in regulation of T cell clonal expansion; involved in regulation of T-cell clonal expansion; lymphokine; M-IL-2; T cell growth factor; T-cell growth factor; T-cell growth factor (TCGF); TCGF
基因别名: IL-2; IL2; lymphokine; TCGF
UniProt ID: (Human) P60568, (Mouse) P04351
Entrez Gene ID: (Human) 3558, (Mouse) 16183